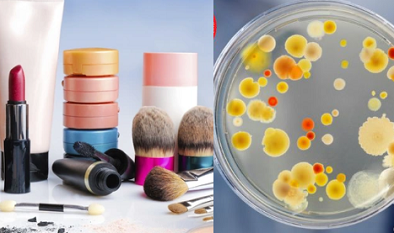
TCVN 13641:2023 hướng dẫn đánh giá và nhận diện mỹ phẩm có rủi ro thấp về mặt vi sinh

Trang chủ

TCVN 13686:2023 về xác định đặc tính của tấm lát sàn gỗ xốp dạng liên kết hạt
(VietQ.vn) - Trước sự phát triển nhanh của thị trường vật liệu lát sàn, việc áp dụng tiêu chuẩn quốc gia cho tấm lát sàn gỗ xốp dạng liên kết hạt trở thành cơ sở quan trọng để kiểm soát chất lượng, bảo vệ người tiêu dùng.
-

Bổ sung hoạt động giảm nhẹ phát thải khí nhà kính, phát triển thị trường carbon và bảo vệ tầng ozone
Giảm tác hại của một số hóa chất trong xe ô tô để bảo vệ sức khỏe
Triển khai các nhiệm vụ, giải pháp trọng tâm thúc đẩy tăng trưởng, kiểm soát lạm phát, ổn định kinh tế vĩ mô
Áp dụng chính sách và phát triển nhiều công nghệ sản xuất thuốc mang tính đột phá
Quảng Trị: Kiểm tra xử lý cơ sở kinh doanh thuốc BVTV, thức ăn chăn nuôi vi phạm chất lượng
Quy định mới về quản lý nhập khẩu hàng hóa tân trang
Nước giải khát theo tiêu chuẩn nào bị đề xuất áp thuế tiêu thụ đặc biệt?
-
Châu Âu ban hành tiêu chuẩn kiểm soát rủi ro hóa chất trong sản phẩm chăm sóc trẻ em
-

Lấy năng suất chất lượng làm động lực phát triển kinh tế tỉnh Cao Bằng giai đoạn 2026–2030
Tin mới 24h

Đề xuất cấm bán thuốc trên mạng xã hội
(VietQ.vn) - Bộ trưởng Y tế Đào Hồng Lan thừa ủy quyền Thủ tướng trình bày Tờ trình về dự án Luật sửa đổi, bổ sung một số điều của Luật Dược. Trong đó có nội dung đáng chú ý là đề xuất bỏ quy định phải có xác nhận của cơ quan quản lý nhà nước khi quảng cáo thuốc và cấm bán thuốc trên mạng xã hội.

Siết chặt hoạt động quảng cáo sản phẩm, hàng hóa của người nổi tiếng
(VietQ.vn) - Việc người nổi tiếng lợi dụng uy tín cá nhân để quảng cáo cho nhiều sản phẩm, trong khi chất lượng chưa được kiểm chứng gây bức xúc dư luận. Do đó, tại dự thảo Luật sửa đổi, bổ sung một số điều của Luật Quảng cáo đang được lấy ý kiến, Bộ Văn hóa Thể thao và Du lịch đề xuất: Khi đăng tải ý kiến, cảm nhận về việc sử dụng hàng hóa, dịch vụ trên mạng xã hội, người quảng cáo phải có bằng chứng cụ thể về việc trực tiếp sử dụng sản phẩm.

Thử nghiệm tiêu chuẩn cho mũ bảo hiểm dùng trong thể thao
(VietQ.vn) - Ủy ban thiết bị thể thao, bề mặt thi đấu và cơ sở vật chất của ASTM International (F08) đang nghiên cứu tiêu chuẩn WK81691 để kiểm tra hiệu suất mũ bảo hiểm trong quá trình tải quay.

Chống hàng giả trên mạng: Ứng dụng công nghệ trong truy xuất nguồn gốc để ngăn chặn
(VietQ.vn) - Theo các chuyên gia, việc ngăn chặn hàng giả trên không gian mạng ngày càng khó khăn cần có nguồn nhân lực, nhất là công cụ, phương pháp phù hợp như ứng dụng công nghệ trong truy xuất nguồn gốc để ngăn chặn.

Nâng cao cảnh giác trước chiến dịch tấn công có chủ đích APT mới nhắm vào Việt Nam
(VietQ.vn) - Mới đây, Cục An toàn thông tin (Bộ Thông tin và Truyền thông) đã phát cảnh báo về các chiến dịch tấn công mới của nhóm "Mustang Panda" nhằm vào Việt Nam.

Gia Lai: Xây dựng mã số vùng trồng khẳng định chất lượng nông sản
(VietQ.vn) - Việc xây dựng mã số vùng trồng cho các sản phẩm nông sản như cà phê, hồ tiêu, sầu riêng, chanh leo, chuối... đã trở thành một phần không thể thiếu trong chiến lược nâng cao giá trị xuất khẩu của tỉnh Gia Lai.
TCVN 13641:2023 hướng dẫn đánh giá và nhận diện mỹ phẩm có rủi ro thấp về mặt vi sinh
(VietQ.vn) - Tiêu chuẩn quốc gia TCVN 13641:2023- ISO 29621:2017 về mỹ phẩm- vi sinh vật- hướng dẫn đánh giá rủi ro và nhận diện các sản phẩm có rủi ro thấp về mặt vi sinh.

Thay đổi thời gian công bố số liệu thống kê CPI, GDP, GRDP
(VietQ.vn) - Các thông tin thống kê quan trọng như: chỉ số giá tiêu dùng (CPI), tăng trưởng tổng sản phẩm quốc nội (GDP) và tổng sản phẩm trên địa bàn (GRDP) sẽ được điều chỉnh thời gian công bố.
.













